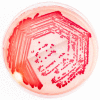

Helicobacter Pylori: A Review of Current Treatment Options in Clinical Practice
- PMID: 36556402
- PMCID: PMC9785457
- DOI: 10.3390/life12122038
Helicobacter Pylori: A Review of Current Treatment Options in Clinical Practice
Abstract
Background: When prescribing antibiotics, infection eradication rates, local resistance rates, and cost should be among the most essential considerations. Helicobacter pylori is among the most common infections worldwide, and it can lead to burdensome sequela for the patient and the healthcare system, without appropriate treatment. Due to constantly fluctuating resistance rates, regimens must be constantly assessed to ensure effectiveness.
Methods: This was a narrative review. The sources for this review are as follows: searching on PubMed, Google Scholar, Medline, and ScienceDirect; using keywords: Helicobacter pylori, Treatment Options, Clinical Practice.
Results: Multiple antibiotics are prescribed as part of the regimen to thwart high resistance rates. This can lead to unwanted adverse reactions and adherence issues, due to the amount and timing of medication administration, which also may contribute to resistance. Single-capsule combination capsules have reached the market to ease this concern, but brand-only may be problematic for patient affordability. Due to the previously mentioned factors, effectiveness and affordability must be equally considered.
Conclusions: This review will utilize guidelines to discuss current treatment options and give cost considerations to elicit the most effective regimen for the patient.
Keywords: Helicobacter pylori; clinical practice; treatment options.
Conflict of interest statement
The authors declare no conflict of interest.
Figures

References
-
- Hooi J.K.Y., Lai W.Y., Ng W.K., Suen M.M.Y., Underwood F.E., Tanyingoh D., Malfertheiner P., Graham D.Y., Wong V.W.S., Wu J.C.Y., et al. Global Prevalence of Helicobacter pylori Infection: Systematic Review and Meta-Analysis. Gastroenterology. 2017;153:420–429. doi: 10.1053/j.gastro.2017.04.022. - DOI - PubMed
-
- Kotilea K., Bontems P., Touati E. Epidemiology, Diagnosis and Risk Factors of Helicobacter pylori Infection. In: Kamiya S., Backert S., editors. Helicobacter pylori in Human Diseases: Advances in Microbiology, Infectious Diseases and Public Health Volume 11. Springer International Publishing; Cham, Switzerland: 2019. pp. 17–33. Advances in Experimental Medicine and Biology.
Publication types
LinkOut - more resources
Full Text Sources

